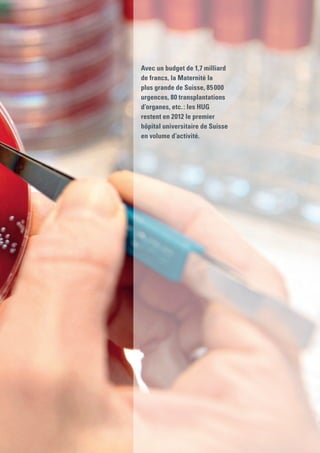
Avec un budget de 1,7 milliard
de francs, la Maternité la
plus grande de Suisse, 85 000
urgences, 80 transplantations
d’organes, etc. : les HUG
restent en 2012 le premier
hôpital universitaire de Suisse
en volume d’activité.

En 2012, les Hôpitaux Universitaires de Genève ont traversé des changements majeurs avec l'instauration de nouvelles normes fédérales et des défis accrus liés à la concurrence entre hôpitaux. Le rapport annuel présente les principales activités, innovations et valeurs de l'institution, tout en soulignant son engagement envers la qualité des soins et l'accès à des traitements de pointe pour les patients. Les HUG, en tant que premier hôpital universitaire de Suisse, continuent de jouer un rôle clé dans le domaine médical, scientifique et sociétal, avec un accent sur la coopération internationale et le développement durable.